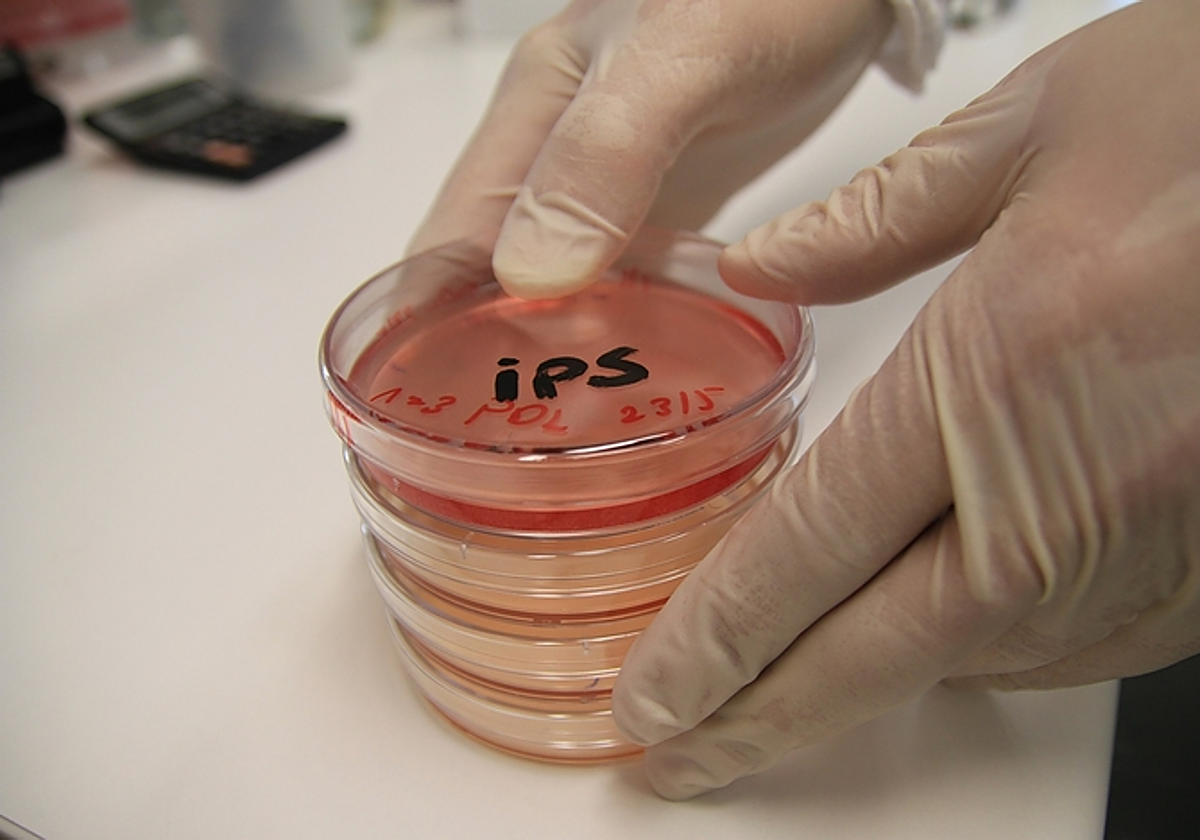
La EPOC necesita desesperadamente tratamientos nuevos y más eficaces

La medicina regenerativa basada en células madre, esperanza para curar la EPOC
La EPOC mata aproximadamente a tres millones de personas en todo el mundo cada año y necesita desesperadamente tratamientos nuevos y más eficaces
Llega el trasplante de células madre de nueva generación para los cánceres de sangre

Esta funcionalidad es sólo para registrados
Iniciar sesiónUn trasplante de células pulmonares procedentes de los propios pacientes con enfermedad pulmonar obstructiva crónica (EPOC) ha logrado recuperar el tejido dañado. Los resultados, presentados en el Congreso Internacional de la Sociedad Respiratoria Europea, muestran por vez primera que la medicina regenerativa a ... través del autotrasplante de células pulmonares es una posible cura para la EPOC.
De los 20 pacientes que participaron en un ensayo clínico de fase I, 17 pudieron respirar mejor, caminar más y tuvieron una mejor calidad de vida después de recibir este tratamiento experimental.
La EPOC mata aproximadamente a tres millones de personas en todo el mundo cada año. Es una enfermedad respiratoria grave que implica un daño progresivo al tejido pulmonar. El tejido afectado no puede repararse con los tratamientos actuales, sólo aliviarse con medicamentos que ensanchan las vías respiratorias para mejorar el flujo de aire, conocidos como broncodilatadores.
La contaminación del aire afecta al peso de los recién nacidos
ABCLa relación entre el peso al nacer y la salud pulmonar es muy fuerte; los niños con bajo peso al nacer presentan un mayor riesgo de asma y tasas más altas de enfermedades pulmonares
«Los resultados de este ensayo clínico de fase I son alentadores», señala Omar Usmani, del Imperial College de Londres (Reino Unido), y jefe del grupo de la Sociedad Europea de Respiración sobre enfermedades de las vías respiratorias, asma, EPOC y tos crónica.
La EPOC necesita desesperadamente tratamientos nuevos y más eficaces. Desde hace tiempo se investiga el papel de las células madre y progenitoras como posible terapia para la EPOC. Las células madre son capaces de transformarse en cualquier célula del cuerpo, mientras que las progenitoras proceden de las células madre y solo pueden convertirse en células que pertenecen al mismo tejido o órgano y normalmente son utilizadas por el cuerpo para reparar y reemplazar el tejido dañado. Sin embargo, hasta la fecha, los resultados han sido contradictorios, especialmente en el caso de las células madre.
El equipo de Wei Zuo, de la Facultad de Medicina de la Universidad de Tongji, en Shanghai, (China), y científico jefe de Regend Therapeutics Ltd, ha estado investigando si un tipo de célula llamada células progenitoras pulmonares P63+ podría regenerar el tejido pulmonar. dañado por la EPOC.
«La medicina regenerativa basada en células madre y células progenitoras puede ser la mayor, si no la única, esperanza para curar la EPOC», señaló Zuo durante la presentación de los resultados en el congreso.
«Las células progenitoras P63+ son conocidas por su capacidad para regenerar los tejidos de las vías respiratorias, y ya se ha demostrado en experimentos con animales que pueden reparar el tejido epitelial dañado en los alvéolos, los pequeños sacos de aire en los pulmones que desempeñan un papel importante en el intercambio de gases entre el aire respirado y el suministro de sangre a los pulmones», explicó.
En este ensayo clínico de fase I, los investigadores se propusieron investigar la eficacia y seguridad de células progenitoras P63+ obtenidas de los pulmones de 20 pacientes con EPOC, para usarlas para cultivar millones más en el laboratorio, antes de trasplantarlas nuevamente a los pulmones de los pacientes.
La medicina regenerativa basada en células madre y células progenitoras puede ser la mayor, si no la única, esperanza para curar la EPOC
Wei Zuo
Facultad de Medicina de la Universidad de Tongji
«En nuestro ensayo, el 35% de los pacientes tenía EPOC grave y el 53% tenía EPOC extremadamente grave. Por lo general, muchos pacientes con una EPOC tan grave morirán con si la enfermedad progresa», aseguró.
A través de un pequeño catéter que contiene un cepillo se recogieron las células progenitoras de las propias vías respiratorias de los pacientes. A continuación , se clonaron las células para fabricar hasta mil millones más y luego se trasplantaron a los pulmones de los pacientes para reparar el tejido pulmonar dañado.
Los pacientes fueron evaluados dentro de las 24 semanas posteriores al tratamiento para evaluar qué tan bien toleraron el tratamiento y su efectividad.
«Descubrimos que el trasplante de células progenitoras P63+ no solo mejoró la función pulmonar de los pacientes con EPOC, sino que también alivió sus síntomas, como dificultad para respirar, pérdida de la capacidad de hacer ejercicio y tos persistente. Esto significa que los pacientes podrían vivir una vida mejor y, normalmente, con una esperanza de vida más larga», afirmó Zuo.
En una persona con EPOC, si progresa el enfisema, aumenta el riesgo de muerte. En este ensayo, añadió, «hemos descubierto que el trasplante de células progenitoras P63+ podría reparar el enfisema leve, haciendo desaparecer el daño pulmonar. No obstante, todavía no podemos reparar el enfisema grave».
A raíz de estos prometedores resultados se ha diseñado un ensayo de fase II que evaluará su eficacia en un grupo más grande de pacientes.
También se está probando una estrategia terapéutica similar en pacientes con enfermedades fibróticas pulmonares letales, incluida la fibrosis pulmonar idiopática. «Vamos a probar la eficacia del tratamiento en grupos más grandes de personas con más enfermedades pulmonares. Esperamos desarrollar el tratamiento para uso clínico dentro de dos o tres años», adelantó Zuo.
Esta funcionalidad es sólo para suscriptores
Suscribete
Esta funcionalidad es sólo para registrados
Iniciar sesiónEsta funcionalidad es sólo para suscriptores
Suscribete